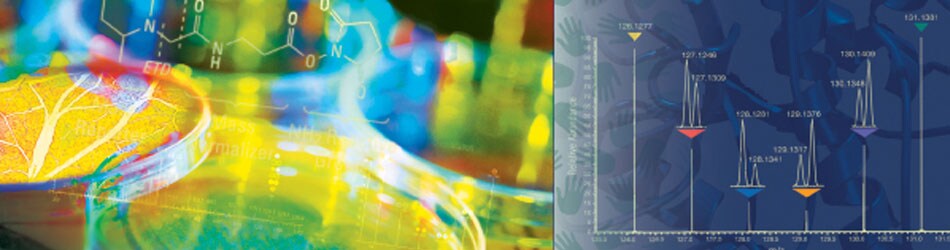

Search
Search
质谱样品制备 | 发现型定量蛋白质组 | 靶向型定量蛋白质组
赛默飞定量蛋白质组学技术巡讲,将通过对定量蛋白质组学技术专题的介绍,展示应用定量蛋白质组学进行发现型和靶向型定量研究的方法,包括样品制备流程,多重定量技术,免疫沉淀-质谱联用技术,以及基于OrbitrapTM 平台开发的新工具。
北京
| 时间 | 地点和题目 |
| 2015.7.20 13:30 / 16:00 | 中国医学科学院基础所老楼一层 1.质谱样品处理和多重定量技术简介 2.提高基于质谱的蛋白定量分析:利用IP-MS分析AKT/mTOR通路蛋白 3.基于OrbitrapTM 超高分辨质谱平台的多重标记定量蛋白质组学新进展 |
| 2015.7.21 09:00 / 11:30 | 中国科学院发育遗传所2号楼 1.提高基于质谱的蛋白定量分析:利用IP-MS分析AKT/mTOR通路蛋白 2.基于OrbitrapTM 超高分辨质谱平台的多重标记定量蛋白质组学新进展 |
| 2015.7.21 14:00 / 16:30 | 国家蛋白质组中心 (BPRC) 1.多重定量TMT技术和应用的介绍 2.基于OrbitrapTM 超高分辨质谱平台的多重标记定量蛋白质组学新进展 |
上海
| 时间 | 地点和题目 |
| 2015.7.22 14:00 / 16:00 | 中国科学院上海药物研究所 1.多重定量TMT技术和应用的介绍 2.基于OrbitrapTM 超高分辨质谱平台的多重标记定量蛋白质组学新进展 |
| 2015.9.15 13:30 / 15:30 | 中国科学院生物化学与细胞生物学研究所 1.提高基于质谱的蛋白定量分析:利用IP-MS分析AKT/mTOR通路蛋白 2.基于OrbitrapTM 超高分辨质谱平台的多重标记定量蛋白质组学新进展 |
| 2015.9.16 13:30 / 15:30 | 复旦大学医学院 1.提高基于质谱的蛋白定量分析:利用IP-MS分析AKT/mTOR通路蛋白 2.基于OrbitrapTM 超高分辨质谱平台的多重标记定量蛋白质组学新进展 |
广州
| 时间 | 地点和题目 |
| 2015.7.23 9:30 / 11:30 | 广东省农科院 1.质谱分析中亚蛋白质组富集和样品处理策略 2.多重定量TMT技术和应用的介绍 |
| 2015.7.24 9:30 / 11:30 | 中山医科大学 1.提高基于质谱的蛋白定量分析:利用IP-MS分析AKT/mTOR通路蛋白 2.基于OrbitrapTM 超高分辨质谱平台的多重标记定量蛋白质组学新进展 |
大连
| 时间 | 地点和题目 |
| 2015.8.20 13:30 / 15:30 | 中国科学院大连化学物理研究所 1.基于OrbitrapTM 超高分辨质谱平台的多重标记定量蛋白质组学新进展 2.提高基于质谱的蛋白定量分析:利用IP-MS分析AKT/mTOR通路蛋白 |
如欲了解更多信息,请与负责销售联系
| 城市 | 地点 | 负责销售 |
| 北京 | 中国医科院协和基础所 | 刁鹏举 186-1106-7371 |
| 北京 | 中国科学院遗传与发育研究所 | 黄荣桂 186-0117-1675 |
| 北京 | 国家蛋白质组中心(BPRC) | 魏 薇 186-1106-7297 |
| 上海 | 中国科学院上海药物所/生物化学与细胞生物学研究所 | 喻义赣 185-0176-2020 |
| 广州 | 广东省农科院 | 周 建 186-2028-2690 |
| 广州 | 中山医科大学 | 周 建 186-2028-2690 |
| 广州 | 广东省农科院 | 周 建 186-2028-2690 |
| 大连 | 中国科学院大连化学物理研究所 | 李左栋 189-4027-8168 |
| 上海 | 复旦大学医学院 | 李程鹏 185-1211-9566 |